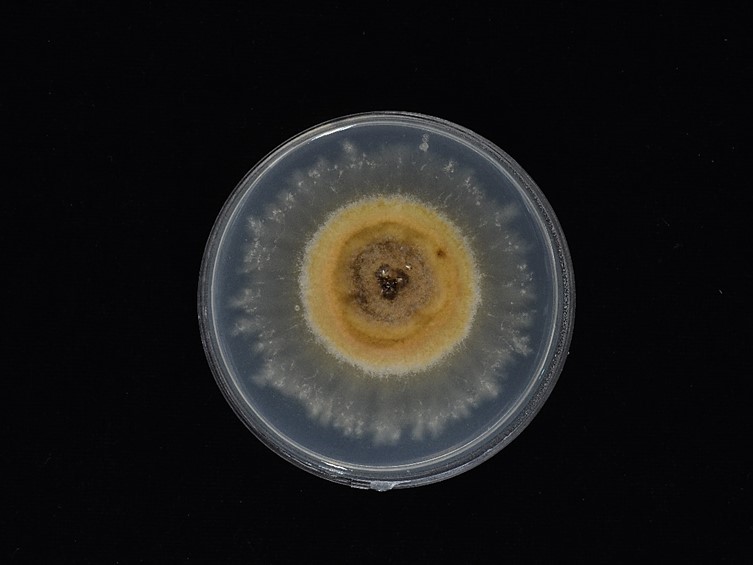

Holotype:
THAILAND, Uthai Thani Province, Huai Kha Khaeng Wildlife Sanctuary, 28 Aug. 2003, N.L. Hywel-Jone, holotype BBH 9008, ex-type living culture BCC 14478.
Habitat:
Buried in the soil.
Host:
Termite.
Description:
 Stroma solitary, simple or branched, narrowly clavate, slender and wiry, up to 9.5 cm long, 0.5 mm wide. Fertile head cylindric, orange brown to red brown up to 8 mm long, 1 mm wide.
Stroma solitary, simple or branched, narrowly clavate, slender and wiry, up to 9.5 cm long, 0.5 mm wide. Fertile head cylindric, orange brown to red brown up to 8 mm long, 1 mm wide.  Perithecia immersed, ovoid, ordinal in arrangement, 300-403 × 130-200 µm. Asci 8-spored, cylindrical, 155-225 × 4.5-8 µm. Ascospores whole, filiform, 156.5-197.5 × 2-3 µm, with septa.
Perithecia immersed, ovoid, ordinal in arrangement, 300-403 × 130-200 µm. Asci 8-spored, cylindrical, 155-225 × 4.5-8 µm. Ascospores whole, filiform, 156.5-197.5 × 2-3 µm, with septa.
Culture characteristics:
Colony on PDA attaining a diam of 25 mm within 20 d at 25 °C, orange to orange brown. Conidiogenous cells monophialidic, arising from hyphae laterally or terminally, hyaline, tapering gradually or abruptly into a long slender neck, 32–50 µm long, 2–3µm wide at the base, 1–1.5 µm wide at tip with warty surface. Conidia hyaline, one-celled, with distinct gold cap covering the tip of the conidia, fusiform, 12–17 × 2–4 µm. Sclerotia formed in culture after 1 month, dark brown.
Colony on PDA attaining a diam of 25 mm within 20 d at 25 °C, orange to orange brown. Conidiogenous cells monophialidic, arising from hyphae laterally or terminally, hyaline, tapering gradually or abruptly into a long slender neck, 32–50 µm long, 2–3µm wide at the base, 1–1.5 µm wide at tip with warty surface. Conidia hyaline, one-celled, with distinct gold cap covering the tip of the conidia, fusiform, 12–17 × 2–4 µm. Sclerotia formed in culture after 1 month, dark brown.
Reference:
Tasanathai K, Noisripoom W, Chaitika T, et al. (2019). Phylogenetic and morphological classification of Ophiocordyceps species on termites from Thailand. MycoKeys 56: 101–129.
DOI: https://doi.org/10.3897/mycokeys.56.37636Species |
Strain |
Compound |
Pubchem CID |
Biological activity |
Reference |
|---|
|
Strain |
ITS | LSU | RPB1 | RPB2 | TEF1 |
|---|---|---|---|---|---|
| BCC 14384 | MH754736 | MH753690 | MK751465 | MK751468 | GU797121 |
| BCC 14477 | MH754735 | MH753689 | MK751467 | MK214103 | GU797123 |
| BCC 14478 | MH754734 | MH753688 | MK751466 | MK214102 | GU797122 |